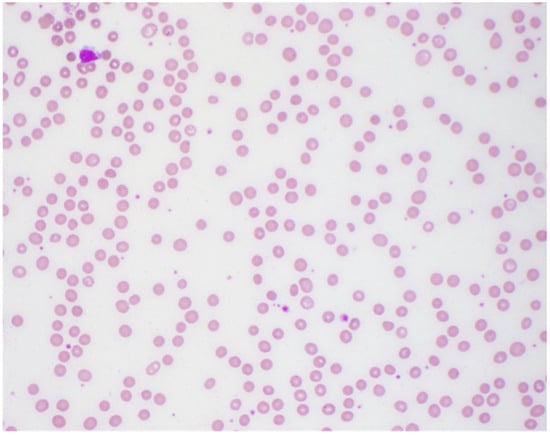

Abstract
Anemia due to acquired copper deficiency is most commonly the result of malabsorption or dietary deficiency. However, it can occasionally be due to excess zinc intake, which impairs the absorption of copper. Copper deficiency may result in vacuolated erythroid and myeloid precursors in the bone marrow, and sometimes features resembling myelodysplasia that, although not specific, may be an important clue to the diagnosis. Background and Clinical Significance: We report bone marrow findings in a child with anemia due to zinc-induced copper deficiency. Case Presentation: An 18-year-old female with cerebral palsy admitted for respiratory failure was found to have anemia and leukopenia with absolute neutropenia. A bone marrow smear showed occasional ring sideroblasts. Additional testing revealed reduced serum copper and elevated serum zinc. Further inquiry uncovered a several-year history of high-dose zinc supplementation. Conclusions: It is important to consider copper deficiency as a potential etiology in patients with anemia and neutropenia, as it may otherwise be mistaken for vitamin B12 deficiency or myelodysplasia. The presence of small vacuoles in hematopoietic precursors is an important clue to the diagnosis and may help avoid ineffective interventions.
1. Introduction and Clinical Significance
Copper deficiency is a rare but well-documented cause of anemia, neutropenia, and sideroblastic anemia [1]. Therefore, it is important to recognize copper deficiency as a potential etiology in patients presenting with cytopenias. Copper deficiency can be due to a variety of reasons, including dietary deficiency, malabsorption, excess excretion, Wilson disease, Menkes syndrome, and excess ingestion of zinc in the form of supplements, dental fixatives, and zinc pennies [2,3,4]. Copper deficiency can lead to reversible hematological and irreversible neurological manifestations [5,6]. However, due to its low prevalence and nonspecific hematological and clinical manifestations, copper deficiency is often misdiagnosed as myelodysplastic syndrome due to similar hematopathological findings [7]. The bone marrow findings of copper deficiency include hypocellularity, vacuolization of erythroid and myeloid precursors, and ring sideroblasts [8,9]. Earlier detection of copper deficiency can avoid future morbidity of neurological deficits, cytopenias, and continued ineffective interventions. In addition, it is important to consider a rare cause of copper deficiency that has been reported more in the elderly population, zinc supplementation [10]. We describe the case of a young adult patient with a complex medical history in whom copper deficiency led to anemia and neutropenia due to long-term supplemental use of high-dose zinc.
2. Case Presentation
Lennox–Gastaut Syndrome
The patient is an 18-year-old female with history of hypoxic–ischemic encephalopathy (HIE) due to non-accidental trauma (NAT), intellectual disability, cerebral palsy (CP), dysphagia with gastrostomy tube (GT), gastroesophageal reflux (GER) status post Nissen fundoplication, Lennox–Gastaut Syndrome (LGS) status post vagus nerve stimulation (VNS) device placement, scoliosis status post spinal fusion, restrictive lung disease, tracheostomy with ventilator dependence, and history of recurrent pneumonias brought to the emergency department (ED) for hypoxia. A few days before presenting to the ED, the patient’s mother reported that her daughter had a seizure that lasted for 20 min that required Diazepam and later noted foul smelling stools, tachycardia, abdominal distension, and increased paleness.
The patient was admitted for respiratory failure. As the etiology for the respiratory failure was being worked up, the initial complete blood count (CBC) with differential reported significant findings of moderate, borderline normocytic (MCV: 96.1 fL) anemia and marked leukopenia with neutropenia, based on the hospital system’s determined reference ranges (Table 1). To rule out a secondary cause of the anemia, tests assessing the levels of bilirubin, vitamin B12, and folic acid were ordered, which were all within normal ranges. The peripheral smear showed moderate normocytic normochromic anemia as shown in Figure 1. After medication reconciliation, it was noted that the patient had a several-year history of Felbamate use to help manage her seizures. While pancytopenia is a known side effect of Felbamate, it did not adequately explain the patient’s newfound anemia as there was no prior abnormal blood cell counts since starting the medication. At this time, a new acute process was suggested with differentials including febrile neutropenia, viral marrow suppression, antiepileptic drug (AED) marrow suppression, and myelodysplastic syndrome (MDS).

Table 1.
CBC with differentials taken in the emergency department (Initial presentation), when copper supplementation was initiated (After two days IV copper chloride), and approximately one month after zinc supplement cessation (One month Post-treatment). The post-treatment CBC demonstrates resolution of the patient’s anemia and neutropenia.
Figure 1.
Peripheral smear showing moderate normocytic normochromic anemia.
A bone marrow biopsy was performed, and the marrow was revealed to be hypocellular for her age (60–70%). There was no histologic evidence of marrow involvement by leukemia, lymphoma, or metastatic malignancy. The bone marrow smears showed multiple small cytoplasmic vacuoles in some of the erythroid precursors and myeloid precursors as shown in Figure 2 and Figure 3, as well as occasional ring sideroblasts (<10%). These findings were recognized as possible signs of copper deficiency and prompted secondary testing for serum copper and zinc. As these serum tests were not available in the hospital laboratory, send-out tests were ordered, and a peripheral blood sample was sent for analysis. Serum copper was markedly decreased (<0.10 mcg/mL) and serum zinc was elevated (1.80 mcg/mL) (Table 2).

Figure 2.
Bone marrow aspirates with cytoplasmic vacuoles seen in erythroid precursors (red arrows).

Figure 3.
Bone marrow aspirates with cytoplasmic vacuoles seen in erythroid (red arrow) and myeloid precursors (black arrow).

Table 2.
Serum zinc and copper level tests. The patient’s zinc levels were taken due to suspicion of zinc toxicity (pre-treatment). The serum copper level test reported an abnormal (low) result, taken due to suspicion of zinc-induced copper deficiency (pre-treatment) and taken approximately one month after zinc supplement cessation (post-treatment).
Further inquiry with the patient’s mother revealed the use of high-dose zinc supplementation for the past three years while on a ketogenic diet as directed by a nutritionist from an outside hospital system. The care team counseled the patient’s family on the effects of zinc supplementation and discontinued its use. The patient was started on IV copper chloride supplementation for 5 days with gradual improvement of the patient’s white blood count and absolute neutrophil count. The chromosomal analysis of the marrow resulted as overall normal. The remainder of the patient’s hospital stay was focused on managing her respiratory symptoms and seizures which were complicated by fever. On admission, the patient was started on antibiotics for concern for pneumonia. However, chest X-rays did not appear to show signs of pneumonia. Sputum trachea aspirate culture was positive with moderate growth of Gram-negative rods, suspicious for Pseudomonas aeruginosa. The patient was then administered the appropriate antibiotics based on the bacterial sensitivities report with improvement of her respiratory symptoms. After it was found that the likely cause of anemia was copper deficiency, the neurologists restarted the patient’s home AED regimen, with improvement of seizure activity. On several occasions the patient’s hemoglobin (Hgb) levels dropped below 7 g/dL, in which she was transfused one unit of red blood cells each time. Upon resolution of her marked anemia, the patient was discharged.
Approximately one month after cessation of zinc supplementation, the patient presented for follow-up. After the 5-day course of IV copper chloride, the patient was prescribed home supplementation of 1 mg copper chloride, until a serum copper level was re-checked. A follow-up CBC and serum copper level was ordered to monitor the patient’s anemia, which reported no abnormalities (Table 1 and Table 2). At this time, the copper supplementation was discontinued. An additional serum zinc level was not ordered by the clinician at this time, as the anemia and copper levels had resolved.
3. Discussion
This case underscores the intricate interactions between copper and zinc, unraveling not only the complexities of micronutrient metabolism but also the diagnostic challenges entwined with differentials.
Zinc, predominantly absorbed in the duodenum and jejunum [11], binds to metallothionein—a primarily intracellular protein regulating various metals, including copper. Excessive zinc stimulates enterocytes to produce more metallothionein, thereby decreasing free zinc concentrations. However, due to copper’s higher affinity to metallothionein than zinc, this leads to a decrease in serum copper levels [12]. Additionally, copper, a crucial cofactor for enzymes in heme biosynthesis, plays a pivotal role in facilitating the insertion of iron into protoporphyrin IX, a process catalyzed by ferrochelatase. Copper deficiency can impede this crucial step in hemoglobin production [13]. Moreover, copper influences intestinal iron absorption through the alteration of DNA-binding proteins and mitochondrial iron homeostasis, contributing to factors that may account for anemia [10,14].
The bone marrow findings, presence of ringed sideroblasts and vacuolated erythroid and myeloid precursors, prompted a clinical investigation into copper and zinc levels. The vacuolated erythroid precursors highlight the impact of copper deficiency on heme synthesis, underscoring the non-specific yet pivotal role of bone marrow examination in guiding the diagnostic process. Based on these findings and the additional copper and zinc serum levels, prompt correction led to the resolution of anemia and leukopenia with neutropenia. This case serves as a testament to the reversible nature of this condition when identified early.
As discussed previously, to determine zinc toxicity, copper levels must be assessed as well. Clinically, copper deficiency can be very difficult to assess, with some cases taking months to years to diagnose. The common manifestations include leukopenia, anemia (microcytic, normocytic, or macrocytic), myelopathy, and peripheral neuropathy. Of note, one pertinent negative lab finding that has been reported in these patients is normal platelet counts [1,2,3,5,7], though this finding requires further studies to confirm significance. Identifying chronic zinc ingestion as the cause is crucial to prevent irreversible consequences, such as ascending sensorimotor polyneuropathy syndrome, especially in patients with preexisting neurological impairment.
Beyond copper deficiency, vacuolated erythroid and myeloid precursors can be associated with various conditions, including Pearson syndrome [15], myelodysplastic syndromes [9], acute alcoholic intoxication [16], and Menkes disease [17]. However, several important negative findings collectively ruled these differential diagnoses less likely: the uneventful chromosomal analysis result and the absence of dysplastic features in the bone marrow; the lack of significant past medical history, laboratory findings, and family history related to these diagnoses.
4. Conclusions
We report a rare case of zinc-induced copper deficiency causing anemia and discuss its pathophysiology. This case emphasizes the importance of utilizing histologic features and understanding cellular and molecular mechanisms to connect the dots in a clinical puzzle. Copper’s role in hemoglobin synthesis as well as zinc’s regulatory effect contributes to the broader literature on the intricate interplay between zinc and copper metabolism. There are very few reports of zinc-induced copper deficiency, with none reporting on young adult patients or patients with multiple comorbidities that includes GT dependence. In addition, this case highlights the importance of a thorough history and physical exam and chart review.
Based on the rapid recovery of this patient’s neutropenia, IV copper chloride supplementation may be considered in the management of zinc-induced copper deficiency. As this patient had dysphagia and was GT-dependent, we did not explore oral copper supplementation; however, there is one report of an elderly patient that demonstrated sufficient treatment with oral copper gluconate over several months [10,18]. Consultation with a nutritionist and pediatric oncologist are essential for managing patients with multiple comorbidities and critical presentations.
Healthcare professionals, armed with a nuanced understanding of these mechanisms, can navigate the delicate balance of micronutrients for optimal patient care. As we unravel the complexities of zinc-induced copper deficiency anemia, we gain insights not only into pathophysiology but also elevate our awareness of the significance of early intervention in preventing potential complications.
Author Contributions
Conceptualization, J.W.; writing—original draft preparation, N.C., S.A., and D.X.; writing—review and editing, N.C., S.A., D.X., J.W., C.Z., and A.K.; visualization, N.C., S.A., and J.W.; supervision, J.W. All authors have read and agreed to the published version of the manuscript.
Funding
This research received no external funding.
Institutional Review Board Statement
According to the guidelines of the Loma Linda University Institutional Review Board, single-patient case reports are not considered research and therefore do not require ethical approval.
Informed Consent Statement
The patient’s provided oral informed consent for the publication of this case and any accompanying images.
Data Availability Statement
No new data was created in this case report.
Conflicts of Interest
The authors declare no conflicts of interest.
Abbreviations
The following abbreviations are used in this manuscript:
| g | Grams |
| µg/mcg | Microgram |
| dL | Deciliters |
| mL | Milliliters |
| CBC | Complete Blood Count |
| WBC | White blood count |
| RBC | Red blood cells |
| Hgb | Hemoglobin |
| Hct | Hematocrit |
| MCV | Mean corpuscular volume |
| MCH | Mean corpuscular hemoglobin |
| MCHC | Mean corpuscular hemoglobin concentration |
| RDW | Red cell distribution width |
| Plts | Platelets |
| MPV | Mean platelet volume |
References
- Wahab, A.; Mushtaq, K.; Borak, S.G.; Bellam, N. Zinc-induced copper deficiency, sideroblastic anemia, and neutropenia: A perplexing facet of zinc excess. Clin. Case Rep. 2020, 8, 1666–1671. [Google Scholar] [CrossRef] [PubMed]
- Dolcourt, B.A.; Paxton, J.H.; Bora, K.M.; Aaron, C.K. Pennies for your thoughts: A case series of pancytopenia due to zinc-induced copper deficiency in the same patient. Clin. Pract. Cases Emerg. Med. 2019, 3, 341. [Google Scholar] [PubMed]
- Merza, H.; Sood, N.; Sood, R. Idiopathic hyperzincemia with associated copper deficiency anemia: A diagnostic dilemma. Clin. Case Rep. 2015, 3, 819. [Google Scholar] [CrossRef] [PubMed]
- Willis, M.S.; Monaghan, S.A.; Miller, M.L.; McKenna, R.W.; Perkins, W.D.; Levinson, B.S.; Bhushan, V.; Kroft, S.H. Zinc-induced copper deficiency: A report of three cases initially recognized on bone marrow examination. Am. J. Clin. Pathol. 2005, 123, 125–131. [Google Scholar] [CrossRef] [PubMed]
- Halfdanarson, T.R.; Kumar, N.; Li, C.Y.; Phyliky, R.L.; Hogan, W.J. Hematological manifestations of copper deficiency: A retrospective review. Eur. J. Haematol. 2008, 80, 523–531. [Google Scholar] [CrossRef] [PubMed]
- Myint, Z.W.; Oo, T.H.; Thein, K.Z.; Tun, A.M.; Saeed, H. Copper deficiency anemia. Ann. Hematol. 2018, 97, 1527–1534. [Google Scholar] [CrossRef] [PubMed]
- Gregg, X.T.; Reddy, V.; Prchal, J.T. Copper deficiency masquerading as myelodysplastic syndrome. Blood. J. Am. Soc. Hematol. 2002, 100, 1493–1495. [Google Scholar]
- Dunlap, W.M.; James, G.W., III; Hume, D.M. Anemia and neutropenia caused by copper deficiency. Ann. Intern. Med. 1974, 80, 470–476. [Google Scholar] [CrossRef] [PubMed]
- Gurnari, C.; Pagliuca, S.; Durkin, L.; Terkawi, L.; Pagliuca, S.; Awada, H.; Kongkiatkamon, S.; Maciejewski, J.P.; Gurnari, C.; Carraway, H.E.; et al. Vacuolization of hematopoietic precursors: An enigma with multiple etiologies. Blood J. Am. Soc. Hematol. 2021, 137, 3685–3689. [Google Scholar] [CrossRef] [PubMed]
- Gupta, N.; Carmichael, M.F. Zinc-induced copper deficiency as a rare cause of neurological deficit and anemia. Cureus 2023, 15, e43856. [Google Scholar] [CrossRef] [PubMed]
- Maares, M.; Haase, H. A guide to human zinc absorption: General overview and recent advances of in vitro intestinal models. Nutrients 2020, 12, 762. [Google Scholar] [CrossRef] [PubMed]
- Agnew, U.M.; Slesinger, T.L. Zinc Toxicity; StatPearls Publishing: Treasure Island, FL, USA, 2023. [Google Scholar]
- Wagner, G.; Tephly, T. A Possible Role of Copper in the Regulation of Heme Biosynthesis Through Ferrochelatase. Cytochromes P-450 and b5: Structure, Function, and Interaction; Springer: Berlin/Heidelberg, Germany, 1975; pp. 343–354. [Google Scholar]
- Dietz, J.V. Mitochondrial Metal Homeostasis: A Look into Iron and Copper Mobilization Within Mitochondria. Ph.D. Dissertation, The University of Nebraska-Lincoln, Lincoln, NE, USA, 2021. [Google Scholar]
- Yoshimi, A.; Ishikawa, K.; Niemeyer, C.; Grünert, S.C. Pearson syndrome: A multisystem mitochondrial disease with bone marrow failure. Orphanet J. Rare Dis. 2022, 17, 379. [Google Scholar] [CrossRef] [PubMed]
- Yeung, K.-Y.; Klug, P.; Lessin, L. Alcohol-induced vacuolization in bone marrow cells: Ultrastructure and mechanism of formation. Blood Cells 1988, 13, 487–502. [Google Scholar] [PubMed]
- Sayın, S.; Ünal, Ş.; Çetin, M.; Gümrük, F. Vacuolization in myeloid and erythroid precursors in a child with menkes disease. Turk. J. Haematol. Off. J. Turk. Soc. Haematol. 2019, 36, 203–204. [Google Scholar] [CrossRef] [PubMed]
- Fujikawa, H.; Haruta, J. Copper Deficiency: An Overlooked Diagnosis. Cureus 2023, 15, e49139. [Google Scholar] [CrossRef] [PubMed] [PubMed Central]
Disclaimer/Publisher’s Note: The statements, opinions and data contained in all publications are solely those of the individual author(s) and contributor(s) and not of MDPI and/or the editor(s). MDPI and/or the editor(s) disclaim responsibility for any injury to people or property resulting from any ideas, methods, instructions or products referred to in the content. |
© 2025 by the authors. Licensee MDPI, Basel, Switzerland. This article is an open access article distributed under the terms and conditions of the Creative Commons Attribution (CC BY) license (https://creativecommons.org/licenses/by/4.0/).